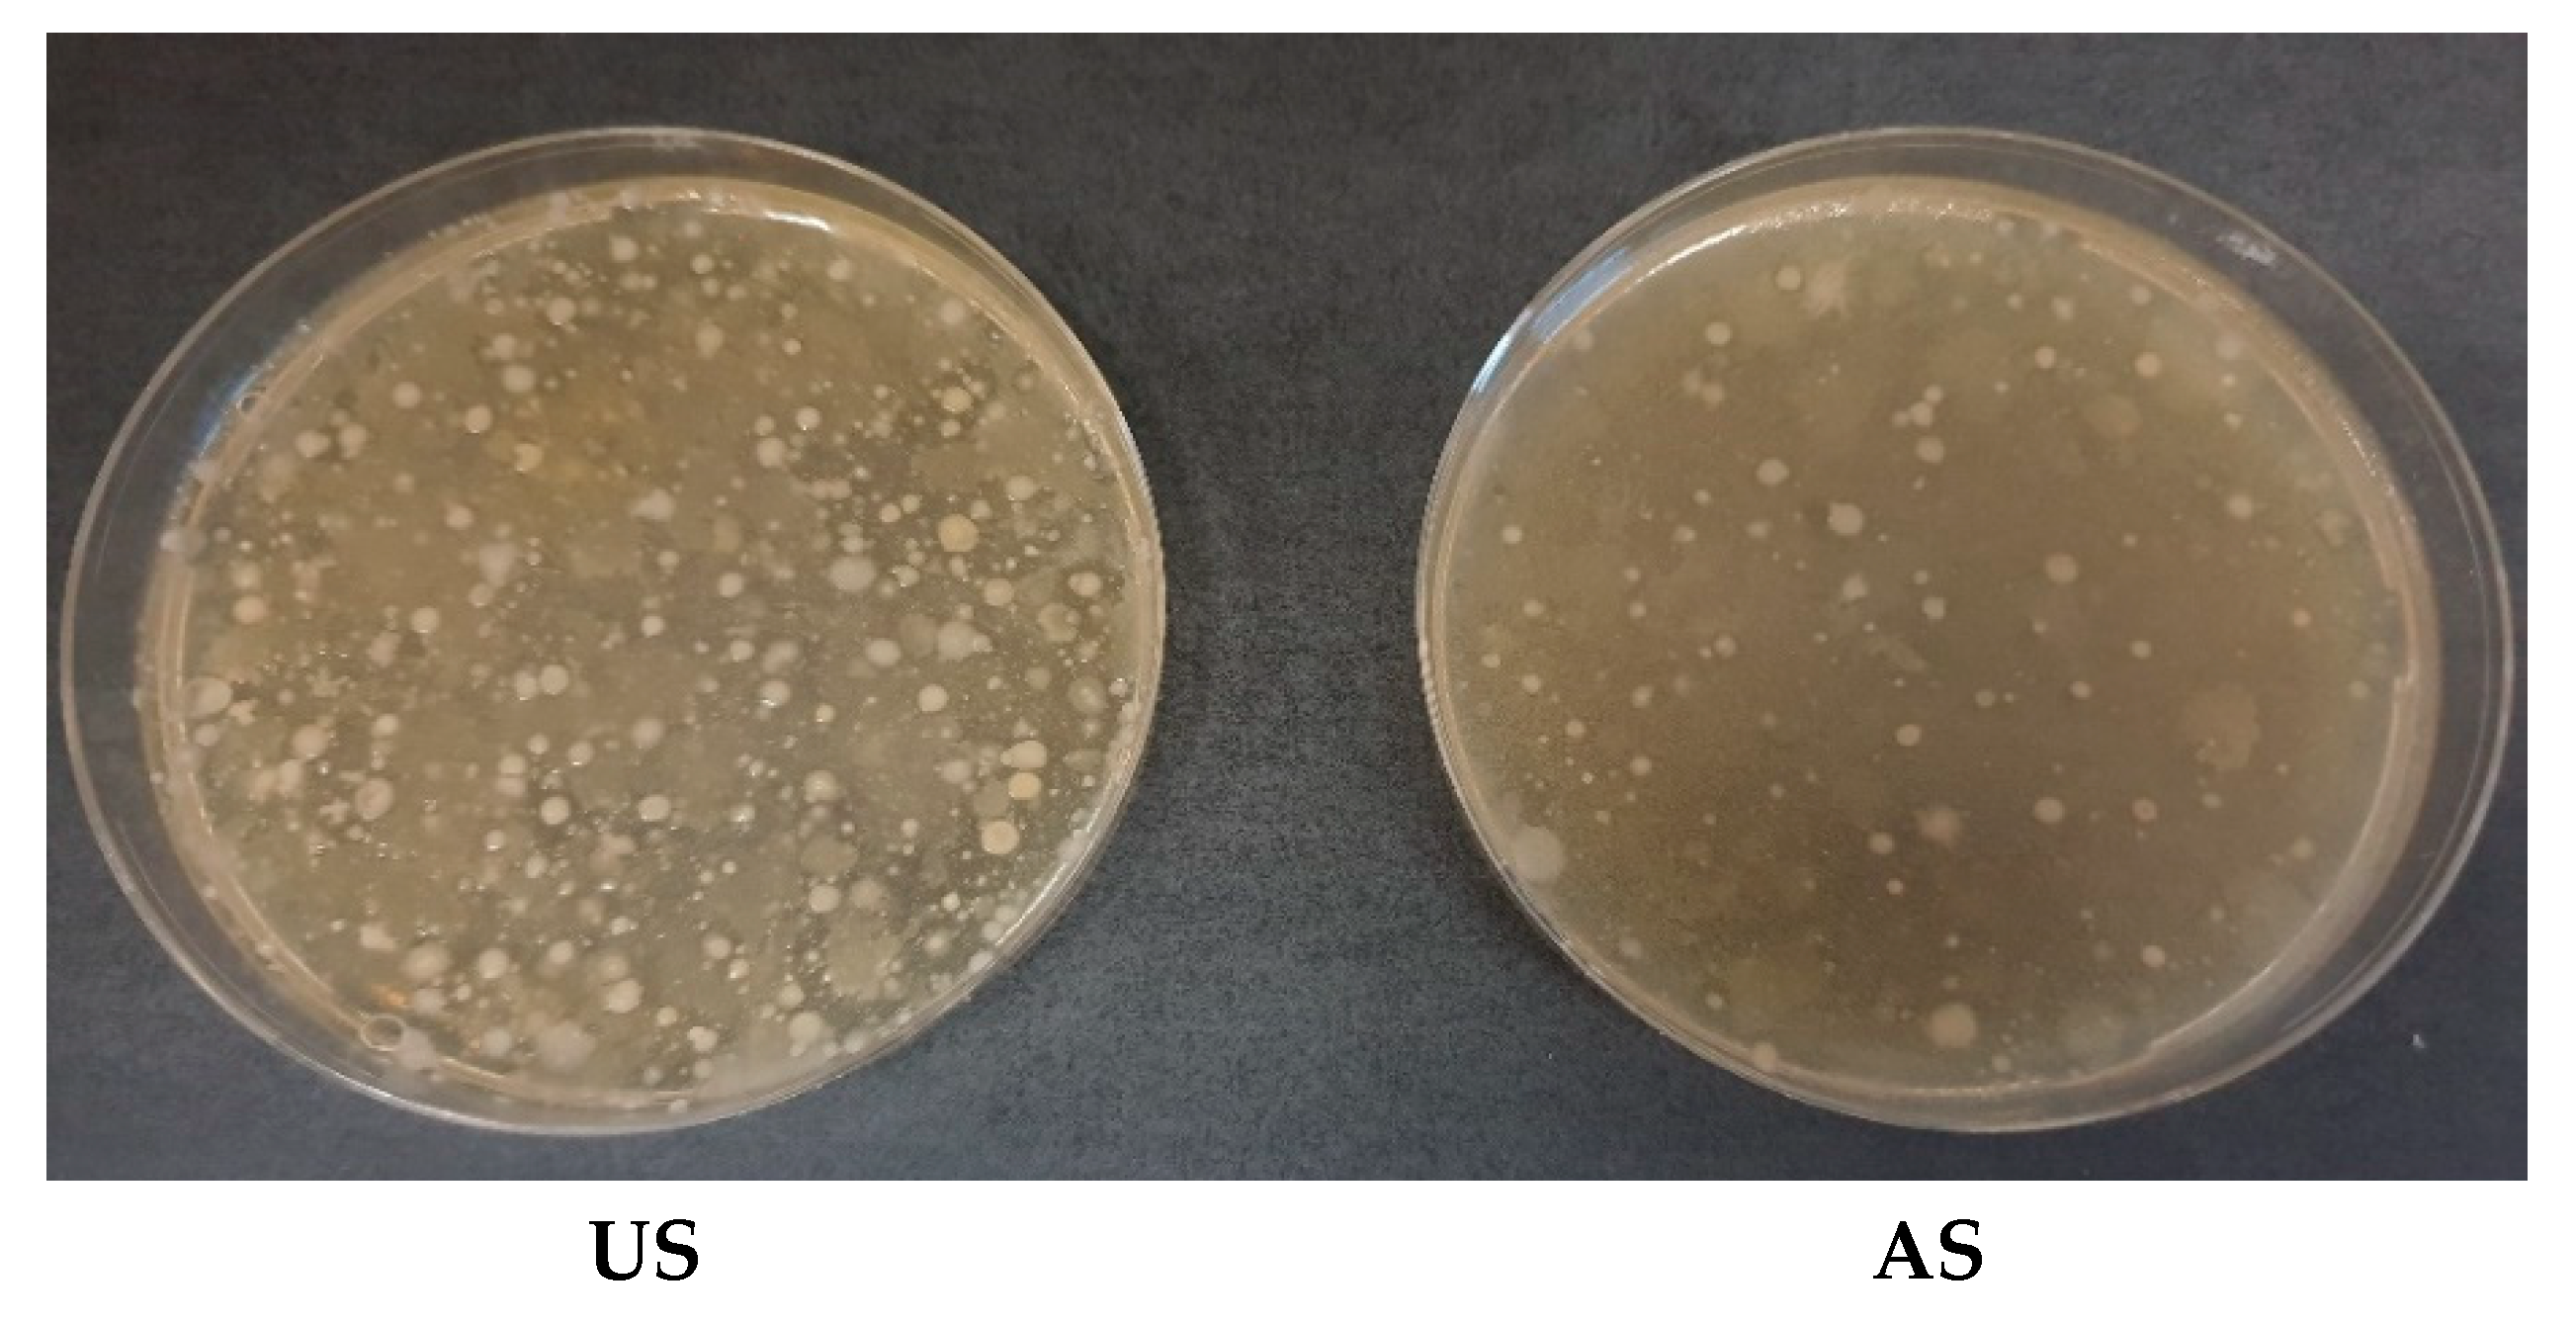
Agriculture 11 00758 g003 550

Aerated Buffalo Slurry Improves Spinach Plant Growth and Mitigates CO2 and N2O Emissions from Soil
Abstract
:1. Introduction
2. Materials and Methods
2.1. Chemical–Physical Characteristics of Liquid Fraction of Slurry
2.2. Fourier-Transform Infrared (FT-IR) and 1H-NMR Measurements
2.3. Microbial Growth and LF Activity
2.4. Seed Germination Test, Plant Growth, Photosynthetic Pigments and Total Phenols, and Heavy Metal Mass Fraction
2.5. Soil CO2 and N2O Fluxes
2.6. Statistical Analysis
3. Results and Discussion
3.1. Effect of Aeration on Chemical–Physical Characteristics of Slurry
3.2. Effect of Aeration on Microbial Growth and Activity
3.3. Seed Germination
3.4. Plant Growth and Metabolites, and Plant–Soil Interaction
3.5. Soil CO2 and N2O Emissions
4. Conclusions
Supplementary Materials
Author Contributions
Funding
Institutional Review Board Statement
Informed Consent Statement
Data Availability Statement
Acknowledgments
Conflicts of Interest
References
- Novak, S.M.; Fiorelli, J.L. Greenhouse gases and ammonia emissions from organic mixed crop-dairy systems: A critical review of mitigation options. Agron. Sustain. Dev. 2010, 30, 215–236. [Google Scholar] [CrossRef] [Green Version]
- Kupper, T.; Hani, C.; Neftel, A.; Kincaid, C.; Buhler, M.; Amon, B.; Van der Zaag, A. Ammonia and greenhouse gas emissions from slurry storage—A review. Agric. Ecosyst. Environ. 2020, 300, 106963. [Google Scholar] [CrossRef]
- Herr, C.; Mannheim, T.; Müller, T.; Ruser, R. Effect of cattle slurry application techniques on N2O and NH3 emissions from a loamy soil. J. Plant Nutr. Soil Sci. 2019, 182, 964–979. [Google Scholar] [CrossRef] [Green Version]
- Herr, C.; Mannheim, T.; Müller, T.; Ruser, R. Effect of nitrification inhibitors on N2O emissions after cattle slurry application. Agronomy 2019, 10, 1174. [Google Scholar] [CrossRef]
- Béline, F.; Martinez, J.; Chadwick, D.; Guiziou, F.; Coste, C.M. Factors affecting nitrogen transformations and related nitrous oxide emissions from aerobically treated piggery slurry. J. Agric. Eng. Res. 1999, 73, 235–243. [Google Scholar] [CrossRef] [Green Version]
- Béline, F.; Martinez, J. Nitrogen transformations during biological aerobic treatment of pig slurry: Effect of intermittent aeration on nitrous oxide emissions. Bioresour. Technol. Rep. 2002, 83, 225–228. [Google Scholar] [CrossRef]
- Amon, B.; Kryvoruchko, V.; Amon, T.; Zechmeister-Boltenstern, S. Methane, nitrous oxide and ammonia emissions during storage and after application of dairy cattle slurry and influence of slurry treatment. Agric. Ecosyst. Environ. 2006, 112, 153–162. [Google Scholar] [CrossRef]
- Molodovskaya, M.; Singurindy, O.; Richards, B.K.; Steenhuis, T.S. Nitrous oxide from aerated dairy manure slurries: Effects of aeration rates and oxic/anoxic phasing. Bioresour. Technol. Rep. 2008, 99, 643–8648. [Google Scholar] [CrossRef] [PubMed]
- Mostafa, E.; Selders, A.; Buescher, W. Aeration of pig slurry affects ammonia and greenhouse gases emissions. Int. J. Environ. Sci. Technol. 2019, 16, 7327–7338. [Google Scholar] [CrossRef]
- He, Z.L.; Yang, X.E.; Stoffella, P.J. Trace elements in agroecosystems and impacts on the environment. J. Trace Elem. Med. Biol. 2005, 19, 125–140. [Google Scholar] [CrossRef]
- Kuiters, A.T. Effects of phenolic acids on germination and early growth of herbaceous woodland plants. J. Chem. Ecol. 1989, 15, 467–479. [Google Scholar] [CrossRef]
- Martinez, C.E.; Motto, H.L. Solubility of lead, zinc and copper added to mineral soils. Environ. Pollut. 2000, 107, 153–161. [Google Scholar] [CrossRef]
- Laraia, R. Metalli totali. In Metodi di Analisi del Compost; Manuale ANPA e Linee Guida; ANPA: Rome, Italy, 2001; Volume 3, Chapter 15; pp. 105–107. [Google Scholar]
- Capri, S.; Pagnotta, R.; Pettine, M. Metodi Analitici Per le Acque; IRSA-CNR Istituto di Ricerca sulle Acque Consiglio Nazionale delle Ricerche: Roma, Italy, 2003; Volume 2, pp. 512–515. [Google Scholar]
- O’Dell, J.W. Methods for the Determination of Inorganic Substances in Environmental Samples (EPA/600/R-93/100); U.S. Environmental Protection Agency: Washington, DC, USA, 1993. [Google Scholar]
- Blainski, L.A.; Lopes, G.C.; Palazzo De Mello, J.C. Application and Analysis of the FolinCiocalteu Method for the Determination of the Total Phenolic Content from Limonium Brasiliense. Molecules 2013, 18, 6852–6865. [Google Scholar] [CrossRef] [PubMed] [Green Version]
- Burns, E.R.; Marshall, C. Correction for chloride interference in the chemical oxygen demand test. J. Water Pollut. Control Fed. 1965, 37, 1716–1721. [Google Scholar] [PubMed]
- Laraia, R. Azoto organico. In Metodi di Analisi del Compost; Manuale ANPA e Linee Guida; ANPA: Rome, Italy, 2001; Volume 3, Chapter 14; pp. 97–99. [Google Scholar]
- Clesceri, L.S.; Eaton, A.D.; Greenberg, A.E. American Public Health Association, American Water Works Association, Federa Water Environment Federation. In Standard Methods for the Examination of Water and Wastewater; American Public Health Association: Washington, DC, USA, 1998. [Google Scholar]
- Memoli, V.; Esposito, F.; De Marco, A.; Arena, C.; Vitale, L.; Tedeschi, A.; Magliulo, V.; Maisto, G. Metal compartmentalization in different biomass portions of Helianthus annuus L. and Sorghum bicolor L. grown an agricultural field inside an urban fabric. App. Soil Ecol. 2017, 121, 118–126. [Google Scholar] [CrossRef]
- Lichtenthaler, H.K. Chlorophylls and carotenoids: Pigments of photosynthetic biomembranes. Methods Enzymol. 1987, 148, 350–382. [Google Scholar]
- Arena, C.; Vitale, E.; Hay Mele, B.; Cataletto, P.R.; Turano, M.; Simoniello, P.; De Micco, V. Suitability of Solanum lycopesicum L. ‘Microtom’ for growth in Bioregenerative Life Support Systems: Exploring the effect of high-LET ionising radiation on photosynthesis, leaf structure and fruit trait. Plant Biol. 2019, 21, 615–626. [Google Scholar] [CrossRef]
- George, B.; Kaur, C.; Khurdiya, D.S.; Kapoor, H.C. Antioxidants in tomato (Lycopersium esculentum) as a function of genotype. Food Chem. 2004, 84, 45–51. [Google Scholar] [CrossRef]
- Costanzo, G.; Iesce, M.R.; Naviglio, D.; Ciaravolo, M.; Vital, E.; Arena, C. Comparative studies on different Citrus cultivars: A revaluation of waste mandarin components. Antioxidants 2020, 9, 517. [Google Scholar] [CrossRef]
- Huang, J.; Yu, Z.; Gao, H.; Yan, X.; Chang, J.; Wang, C.; Hu, J.; Zhang, L. Chemical structures and characteristics of animal manures and composts during composting and assessment of maturity indices. PLoS ONE 2017, 12, e0178110. [Google Scholar] [CrossRef]
- Zhang, Z.; Zhu, J.; Park, K.J. Effects of duration and intensity of aeration on solids decomposition in pig slurry for odour control. Biosyst. Eng. 2004, 89, 445–456. [Google Scholar] [CrossRef]
- Castro-Barros, C.M.; Daelman, M.R.J.; Mampaey, K.E.; van Loosdrecht, M.C.M.; Volcke, E.I.P. Effect of aeration regime on N2O emission from partial nitritation-anammox in a full-scale granular sludge reactor. Water Res. 2015, 68, 793–803. [Google Scholar] [CrossRef] [PubMed]
- Wang, H.; Guan, Y.; Pan, M.; Wu, G. Aerobic N2O emission for activated sludge acclimated under different aeration rates in the multiple anoxic and aerobic process. J. Environ. Sci. 2016, 43, 70–79. [Google Scholar] [CrossRef]
- Calvet, S.; Hunt, J.; Misselbrook, T.H. Low frequency aeration of pig slurry affects slurry characteristics and emissions of greenhouse gases and ammonia. Biosyst. Eng. 2017, 159, 121–132. [Google Scholar] [CrossRef] [PubMed]
- Hu, Z.; Zhang, J.; Xie, H.; Li, S.; Wang, J.; Zhang, T. Effect of anoxic/aerobic phase fraction on N2O emission in a sequencing batch reactor under low temperature. Bioresour. Technol. 2011, 102, 5486–5491. [Google Scholar] [CrossRef]
- Pan, M.; Wen, X.; Wu, G.; Zhang, M.; Zhan, X. Characteristics of nitrous oxide (N2O) emission from intermittently aerated sequencing batch reactors (IASBRs) treating slaughterhouse wastewater at low temperature. Biochem. Eng. J. 2014, 86, 62–68. [Google Scholar] [CrossRef]
- Fangueiro, D.; Hjorth, M.; Gioelli, F. Acidification of animal slurry—A review. J. Environ. Manag. 2015, 149C, 46–56. [Google Scholar] [CrossRef] [PubMed]
- Król, A.; Mizerna, K.; Bożym, M. An assessment of pH-dependent release and mobility of heavy metals from metallurgical slag. J. Hazard Mater. 2020, 384, 121502. [Google Scholar] [CrossRef] [PubMed]
- Bremner, J.M.; Krogmeier, M.J. Evidence that the adverse effect of urea fertilizer on seed germination in soil is due to ammonia formed through hydrolysis of urea by soil urease. Proc. Natl. Acad. Sci. USA 1989, 86, 8185–8188. [Google Scholar] [CrossRef] [Green Version]
- Van Bruchem, J.; Schiere, H.; Van Keulen, H. Dairy farming in the Netherlands in transition towards more efficient nutrient use. Livest. Prod. Sci. 1999, 61, 145–153. [Google Scholar] [CrossRef]
- Schenk, M.; Wehrmann, J. The influence of ammonia in nutrient solution on growth and metabolism of cucumber plants. Plant Soil 1979, 52, 403–414. [Google Scholar] [CrossRef]
- Wang, S.; Guan, K.; Wang, Z.; Ainsworth, E.A.; Zheng, T.; Townsend, P.A.; Li, K.; Moller, C.; Wu, G.; Jiang, C. Unique contributions of chlorophyll and nitrogen to predict crop photosynthetic capacity from leaf spectroscopy. J. Exp. Bot. 2021, 72, 341–354. [Google Scholar] [CrossRef] [PubMed]
- Bustamante, M.Á.; Michelozzi, M.; Caracciolo, A.B.; Grenni, P.; Verbokkem, J.; Geerdink, P.; Safi, C.; Nogues, I. Effects of soil fertilization on terpenoids and other carbon-based secondary metabolites in rosmarinus officinalis plants: A comparative study. Plants 2020, 9, 830. [Google Scholar] [CrossRef]
- Langenkämper, G.; Zörb, C.; Seifert, M.; Mäder, P.; Fretzdorff, B.; Betsche, T. Nutritional quality of organic and conventional wheat. J. Appl. Bot. Food Qual. 2006, 80, 150–154. [Google Scholar]
- Arif, N.; Yadav, V.; Singh, S.; Singh, S.; Ahmad, P.; Mishra, R.K.; Sharma, S.; Tripathi, D.K.; Dubey, N.; Chauhan, D.K. Influence of high and low Levels of plant-beneficial heavy metal ions on plant growth and development. Front. Environ. Sci. 2016, 4, 69. [Google Scholar] [CrossRef]
- Arena, C.; Santorufo, L.; Cataletto, P.R.; Memoli, V.; Scudiero, R.; Maisto, G. Eco-physiological and antioxidant responses of holm oak (Quercus ilex L.) leaves to Cd and Pb. Water Air Soil Pollut. 2017, 228, 459. [Google Scholar] [CrossRef]
- Vitale, L.; Polimeno, F.; Ottaiano, L.; Maglione, G.; Tedeschi, A.; De Marco, A.; Di Tommasi, P.; Magliulo, V. Fertilizer type influences tomato yield and soil N2O emissions. Plant Soil Environ. 2017, 63, 105–110. [Google Scholar]
- Lehtovirta-Morley, L.E. Ammonia oxidation: Ecology, physiology, biochemistry and why they must all come together. FEMS Microbiol. Lett. 2018, 365, fny058. [Google Scholar] [CrossRef] [Green Version]

| Treatment | K (g kg–1) | NH3 (mg kg–1) | NO3 (mg kg–1) | PO4 (g kg–1) | TP (mg kg–1) | Alkalinity (mmol kg–1) | Corg (%) | Norg (mg kg–1) | Cond (mS cm–1) |
|---|---|---|---|---|---|---|---|---|---|
| US | 1.4 ± 0.1 a | 976 ± 2 a | 69.3 ± 0.7 a | 2.6 ± 0.1 a | 288 ± 3 a | 50.2 ± 0.7 a | 0.2 ± 0.1 a | 14.7 ± 0.7 a | 7.1 ± 0.1 a |
| AS24h | 1.4 ± 0.1 a | 370 ± 3 b | 62.8 ± 0.6 b | 3.0 ± 0.1 b | 378 ± 2 b | 92.4 ± 0.8 b | 0.2 ± 0.1 a | 14.6 ± 0.8 a | 7.8 ± 0.1 b |
| Treatment | Pb (mg kg–1) | Cd (mg kg–1) | Cu (mg kg–1) | Zn (mg kg–1) |
|---|---|---|---|---|
| US | 1.7 ± 0.1 a | 1.1 ± 0.1 a | 0.8 ± 0.1 a | 3.6 ± 0.1 a |
| AS24h | 1.4 ± 0.1 b | 0.7 ± 0.1 b | 0.4 ± 0.1 b | 4.8 ± 0.1 b |
| Treatment | Agar (%) | Soil (%) |
|---|---|---|
| Control | 44 a | 50 a |
| US | 0 b | 49 a |
| AS24h | 52 c | 51 a |
| Treatment | Chl (μg cm–2) | Car (μg cm–2) | Phenols (mg GAE g–1 FW) | FRAP (mmol Troloxeq g–1 FW) |
|---|---|---|---|---|
| Control | 61 ± 5 a | 10 ± 6 a | 1.8 ± 0.2 a | 479 ± 5 a |
| US | 53 ± 6 b | 11 ± 1 a | 1.6 ± 0.2 a | 539 ± 14 b |
| AS24h | 47 ± 5 c | 10 ± 3 a | 2.2 ± 0.1 c | 568 ± 17 c |
| Treatments | Pb (mg kg–1 DW) | Cd (mg kg–1 DW) | Cu (mg kg–1 DW) | Zn (mg kg–1 DW) | ||||
|---|---|---|---|---|---|---|---|---|
| Roots | Leaves | Roots | Leaves | Roots | Leaves | Roots | Leaves | |
| Control | 69.5 ± 1.6 a | 57.8 ± 2.0 a | 29.4 ± 6.1 a | 32.9 ± 3.4 a | 44.4 ± 5.4 a | 12.0 ± 0.3 a | 140.3 ± 11.7 a | 102.2 ± 1.8 a |
| US | 98.6 ± 5.9 b | 92.0 ± 1.4 b | 17.5 ± 1.4 b | 26.2 ± 3.4 b | 54.3 ± 3.2 b | 15.6 ± 0.8 b | 107.2 ± 3.7 b | 105.1 ± 7.9 a |
| AS24 | 71.0 ± 12.4 a b | 28.1 ± 2.7 c | 16.6 ± 3.4 b | 18.9 ± 3.3 c | 51.8 ± 4.7 b | 8.3 ± 0.3 c | 80.7 ± 14 c | 77.3 ± 2.0 b |
Publisher’s Note: MDPI stays neutral with regard to jurisdictional claims in published maps and institutional affiliations. |
© 2021 by the authors. Licensee MDPI, Basel, Switzerland. This article is an open access article distributed under the terms and conditions of the Creative Commons Attribution (CC BY) license (https://creativecommons.org/licenses/by/4.0/).
Share and Cite
Maglione, G.; De Tommaso, G.; Iuliano, M.; Costanzo, G.; Vitale, E.; Arena, C.; Vitale, L. Aerated Buffalo Slurry Improves Spinach Plant Growth and Mitigates CO2 and N2O Emissions from Soil. Agriculture 2021, 11, 758. https://doi.org/10.3390/agriculture11080758
Maglione G, De Tommaso G, Iuliano M, Costanzo G, Vitale E, Arena C, Vitale L. Aerated Buffalo Slurry Improves Spinach Plant Growth and Mitigates CO2 and N2O Emissions from Soil. Agriculture. 2021; 11(8):758. https://doi.org/10.3390/agriculture11080758
Chicago/Turabian StyleMaglione, Giuseppe, Gaetano De Tommaso, Mauro Iuliano, Giulia Costanzo, Ermenegilda Vitale, Carmen Arena, and Luca Vitale. 2021. "Aerated Buffalo Slurry Improves Spinach Plant Growth and Mitigates CO2 and N2O Emissions from Soil" Agriculture 11, no. 8: 758. https://doi.org/10.3390/agriculture11080758
APA StyleMaglione, G., De Tommaso, G., Iuliano, M., Costanzo, G., Vitale, E., Arena, C., & Vitale, L. (2021). Aerated Buffalo Slurry Improves Spinach Plant Growth and Mitigates CO2 and N2O Emissions from Soil. Agriculture, 11(8), 758. https://doi.org/10.3390/agriculture11080758

